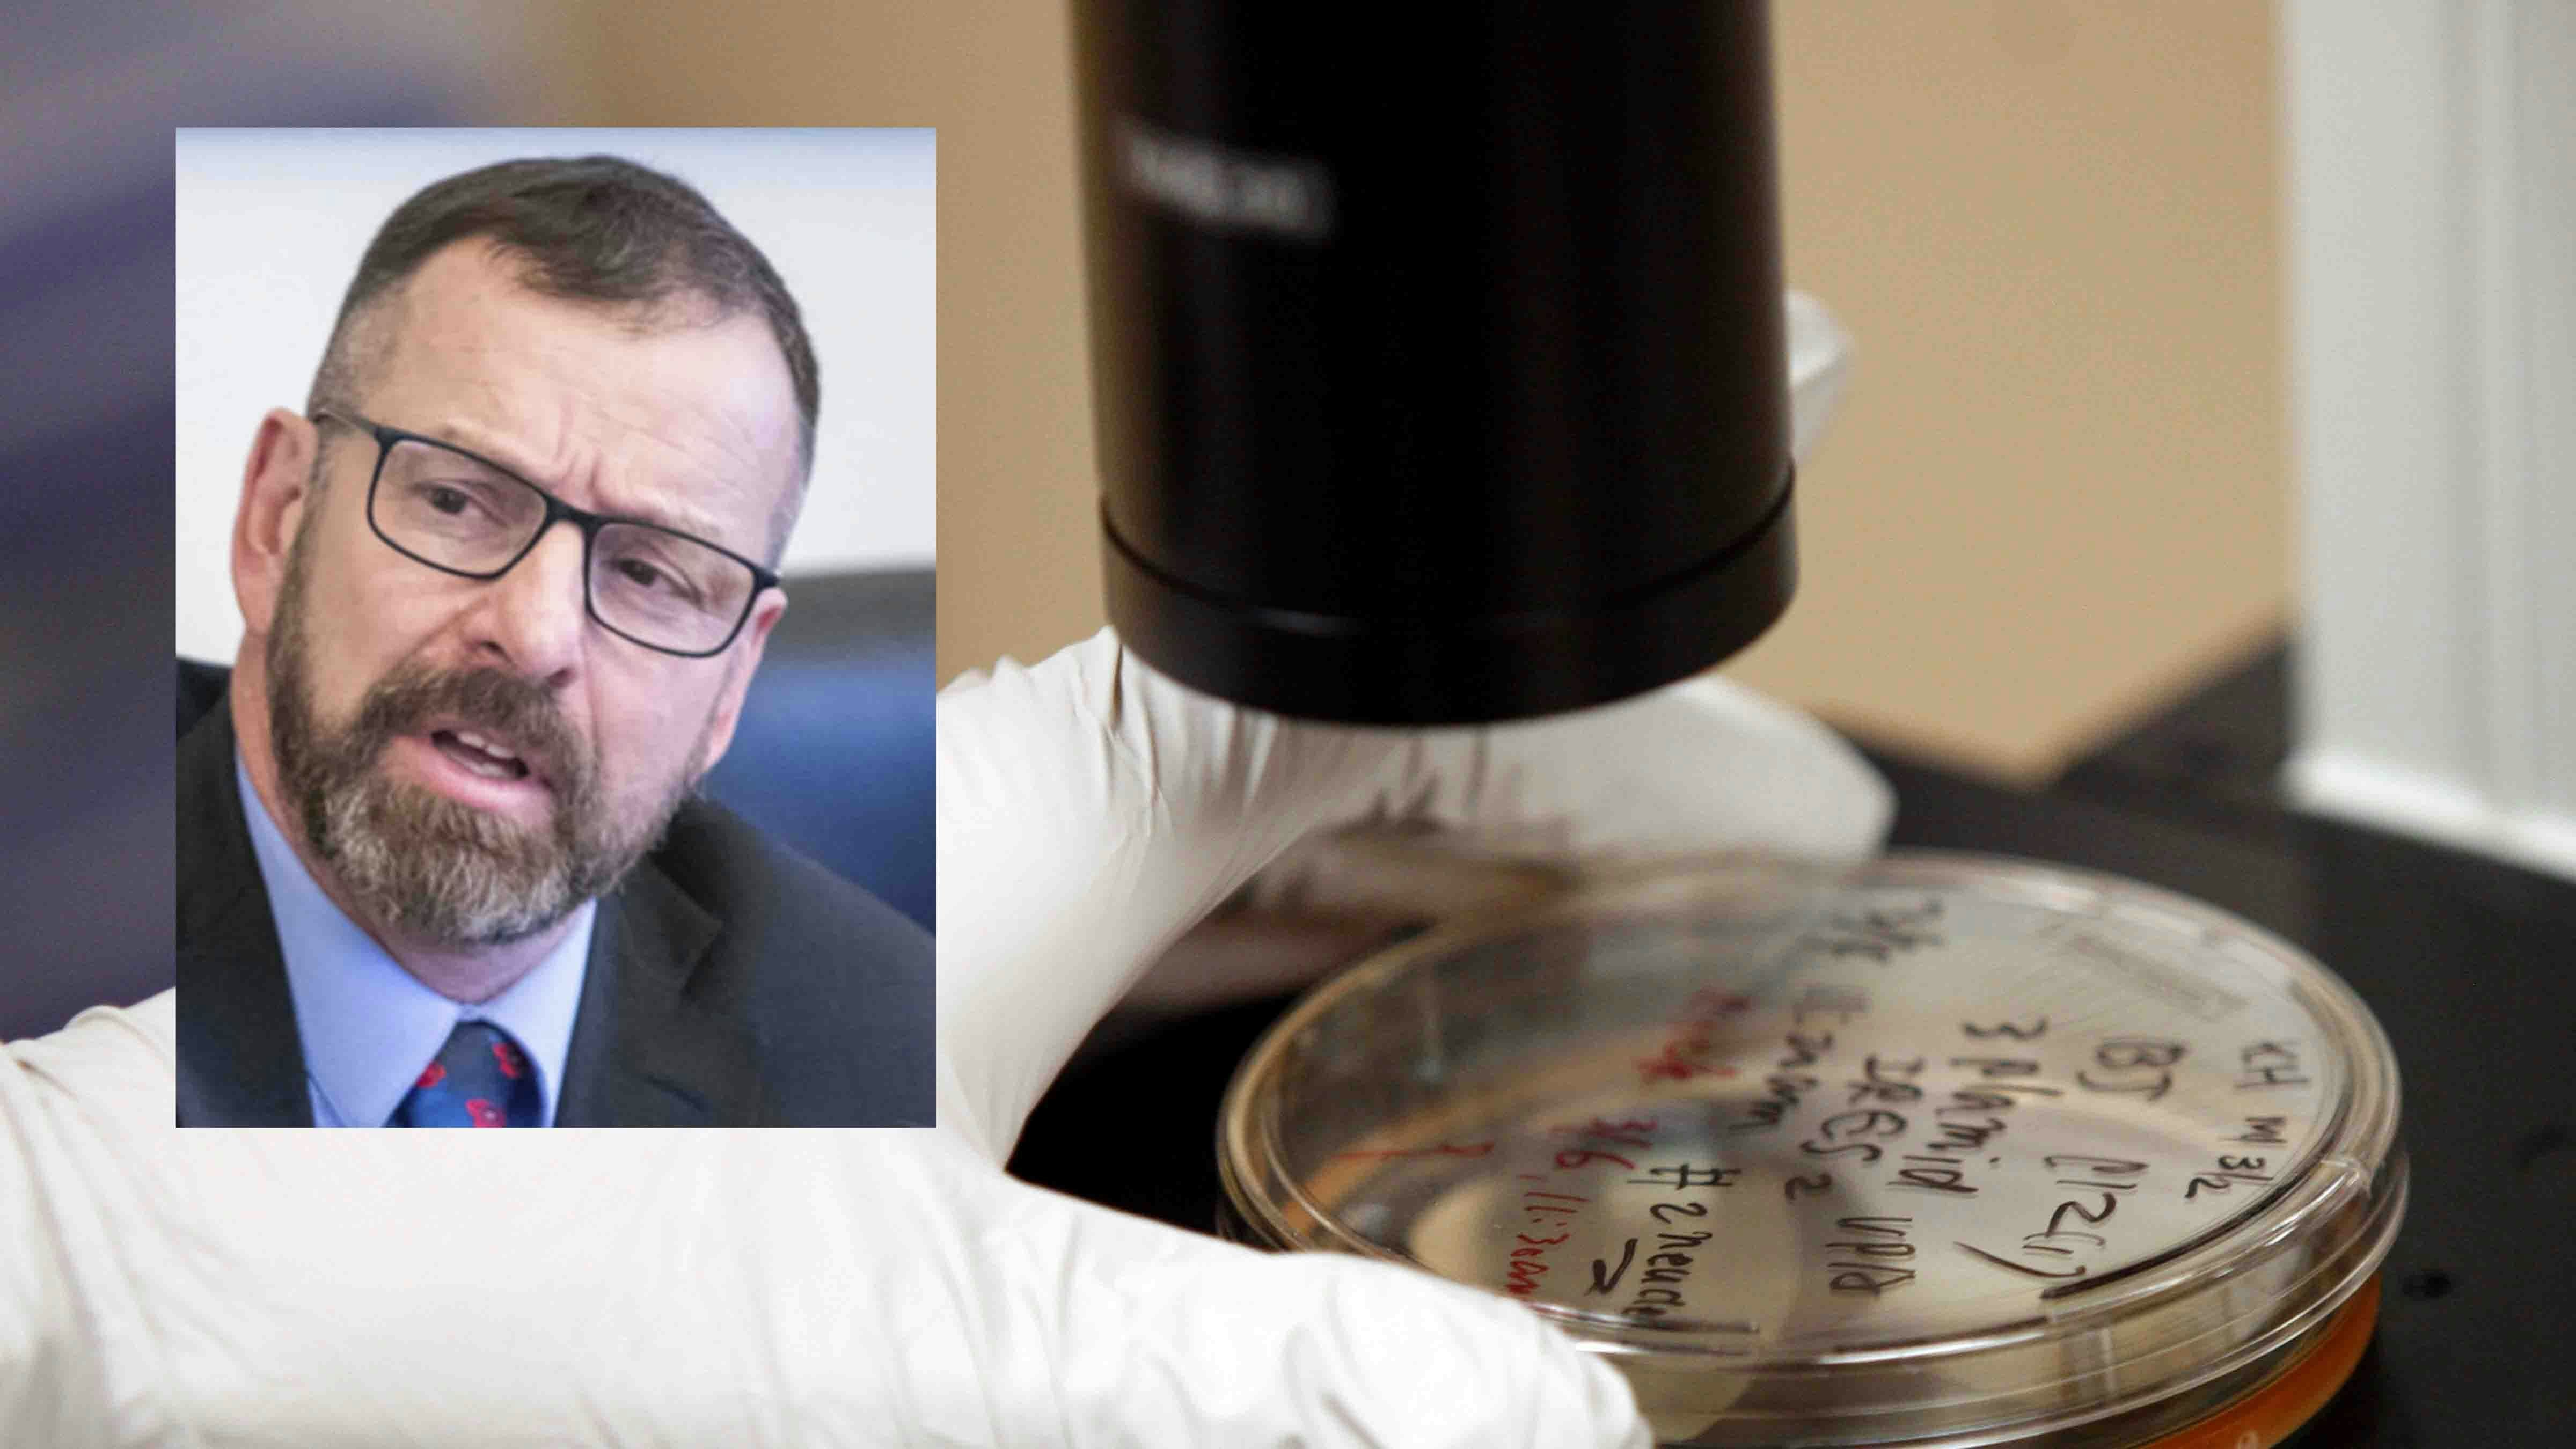
Barlow stem cell 1 28 26

A Wyoming lawmaker is pushing a bill that would allow doctors to perform stem cell treatments not approved by the U.S. Food and Drug Administration (FDA), creating guidelines for treatment while shielding physicians from state licensing discipline.
Sponsored by Sen. Eric Barlow, R-Gillette, The Stem Cell Freedom Act follows in the vein of a “right to try” legal movement which gave terminally ill patients access to experimental drugs and treatments not yet approved by the FDA, including Wyoming's 2015 Right To Try Act.
Barlow says the aim here is similar, to empower individuals with greater medical freedom while assuring a standard of safety.
“Research is showing the very powerful healing of stem cells. This is an effort to give folk access to innate healing abilities while balancing that with assurance and safety,” Barlow told Cowboy State Daily in a Wednesday phone interview.
Under the proposal, doctors would only be protected when providing treatments of “autologous mesenchymal stem cells,” which are stem cells derived from the patient's own body.
In such treatments, the stem cells are typically processed from a person’s fat, bone marrow or connective tissue, then re-injected back into the same person.
To become law, this bill would need to clear a two-thirds introductory vote plus approvals in both chambers - and survive the governor's desk - during the legislative session that opens Feb. 9.
Flies In Face Of FDA
While these treatments are not technically legal when marketed without FDA approval, according to Leigh Turner of the University California Irvine Stem Cell Research Center, stem cell clinics have nonetheless proliferated around the country, with more than 3,000 clinics marketing different forms of the therapy nationwide.
Barlow’s bill flies in the face of the FDA, but it simultaneously aims to bring clarity and more medical accountability to a burgeoning field of medicine.
Under the bill, therapies must either complete a phase one FDA clinical trial or be vetted and approved by an Institutional Review Board (IRB), which would evaluate underlying science, protocols, and proposed use.
The bill requires an established physician-patient relationship for treatment, and that a standard of “informed consent” be established by an IRB.
Proceed With Caution
Some stem cell researchers, however, say the standards of informed consent could fall short.
“One of the concerns is that it puts a bigger burden on patients to manage complex, poorly understood risks,” said Dr. Leigh Turner of the Stem Cell Research Center.
“The risks may be disclosed, but it's important to know that we are talking about stem cell interventions that…have only gone through one study, so they might have been tested on 10 or 12 individuals. That's a very low bar, it’s not rigorous,” said Dr. Leigh Turner of the Stem Cell Research Center.
“When all you’ve got is a phase one study, it becomes much more difficult to even give an honest characterization of risks. There can be unwanted outcomes that aren’t going to make it into informed consent forms because the early clinical research hasn’t even taken place yet.”
Turner offered the example of the U.S. Stem Cell Clinic in Sunrise, Florida, which in 2015 blinded three women after providing an autologous stem cell treatment marketed as a cure for macular degeneration.
Turner also worries that if states champion non-FDA approved treatments, it may encourage medical entrepreneurs to exploit hope without proof of efficacy.
“All over the United States, clinics are marketing claims about stem cells as cures for everything under the sun. But we don’t have good evidence to suggest that,” said Turner. “A lot of money could be changing hands, with people spending a lot of money that they might not even have with a whole lot of hope that's maybe not justified given the lack of efficacy."
Doctor-Patient Relationship Key
Barlow said his bill would help prevent bad actors from hawking false promises, in part by requiring doctor-patient relationships.
“This bill has physicians build relationships with their patients, and evaluate all their different treatment options. If stem cell therapy is a good fit for their condition, then they can move ahead with it,” Barlow said.
“We're actually putting sideboards around it, so that consumer patients have assurance that they're getting a certain standard of treatment.”
The Stem Cell Freedom Act would set Wyoming apart from other state legislation on stem cells.
States like Florida, Utah and Texas have approved bills to allow the use of allogeneic products, or “birth‑tissue” products from things like umbilical cords, according to Turner. But Wyoming’s bill is unusual in its exclusive focus on the patient’s own cells, which are allowed to be cultured and expanded in a lab under the bill.
Whereas states like California, Washington and Vermont have taken the opposite tack, passing laws that focus on consumer protection and patient safety in stem cell treatment.
Barlow believes his bill is a more elegant approach.
“Patient safety in this bill is absolutely paramount. They need to know the risks and potential positive outcomes,” Barlow said. “But I think we’ve got a perfect combination: powerful medicine, the ability to use your own cells for your own healing, and the ability for a doctor to provide that for you.”
Clinic Stance
Charles Hoskinson, founder of the Hoskinson Health and Wellness Clinic in Gillette, welcomed news of the bill in a statement sent Wednesday to Cowboy State Daily.
"The people of Wyoming deserve medical freedom and the right to make their own healthcare decisions,” Hoskinson said in the statement. “They shouldn’t have to travel internationally in order to receive stem cell therapy, they should be able to get it done right here. Similarly, Wyoming doctors shouldn’t have to worry about losing their medical license simply for recommending or providing non-FDA approved stem cell therapy."
Hoskinson extended gratitude to Barlow and the bill's Republican co-sponsors, House Speaker Pro Tempore Jeremy Haroldson (Wheatland), Sen. Evie Brennan (Cheyenne) and Rep. Ken Clouston (Gillette) for the proposed health care innovation.
“The future of stem cell research and therapy is incredibly bright, with new medical breakthroughs taking place each year," Hoskinson added. "Wyoming should be leading the way on medical innovation and patient-centered medical policy rather than waiting for the federal government to catch up with the science."
Zakary Sonntag can be reached at zakary@cowboystatedaily.com.